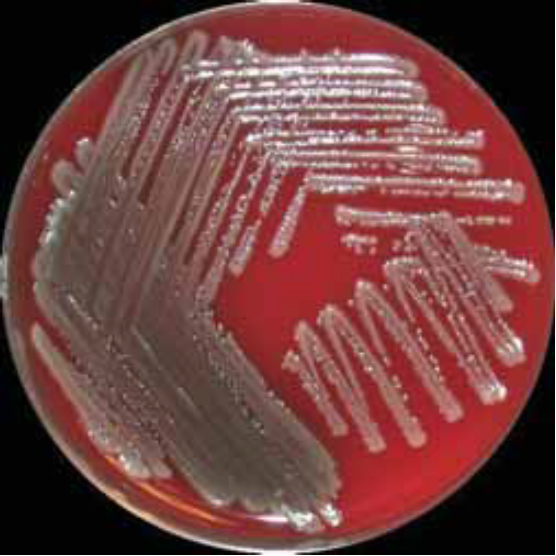
pa metal

İçeriğe geç
- Sinonim: P. aeruginos
- ince, hareketli, gram negatif bakterilerdir.(Bkz; Pseudomonas) (Bkz; aeruginosa)
- obligat aerobtur, oksidaz pozitifdir.
- Saf suda dahi yaşayabilir.
- Bu mikroorganizmayı görüntülemek için kullanılan renklendiriciler;
- Pyocyanin
- Fluorescein
- Pyorubin
- tatlı aromatik kokusu vardır.
Patogenez
- konağın hastalığa yatkınlığı ve enfeksiyon lokasyonuna bağlıdır.
- Duruma göre istilacı özelliği azdır, ama lokal veya sistematik nötrofil granulositlerin azlığına yol açabilir.
- Endotoksin üretir. diğer enterobakterilere kıyasla daha az iltihap yapıcı ve toksiktir.
- Hücre dışı mukus tabakası alginattandır.
- Ekzotoksin A sentezler.
Hastalık belirtileri
- Yanma ve ameliyat yaralarında irine yol açar.
- idrar yolu enfeksiyonuna sebep olup, idrar yaomayı engeller.
- Otitis externa
- Göz bantları altında Keratitise sebep olur.
- Endokarditis
- septikemi
- kistik fibroziste kronik enfeksiyona sebep olur.
Epidemiyoloji
- Her yerde bulunur. Tuvalette, sifonda, diyaliz aletlerinde, nefesimizde v.s.
- Tipik hastane hastalık etkenidir.
Laboratuvar Teşhisi
- Kültür ile üretimde metal parlaklığı saçar.
- Serolojide, ürettiği ekzotoksin A’ya karşı antikor kullanarak tespit edilir.
Tedavi ve Profilaksi
- Antibiyotik
- Acylureidopenicilline
- Ceftazidim, Cefepime, Cefpirom
- Carbapeneme
- Aminoglykoside
- Fluorchinolone
- Polymyxine
- El ve aletlerin hijyenine dikkat edilmelidir.
- Yapısal ve teknik önlemler alınabilir.(örneğin sularda bakteri filtresi kullanılabilir.)